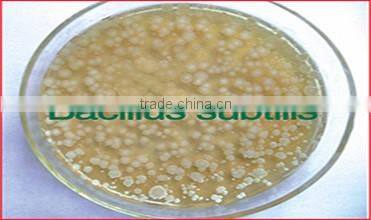

Home > Products > New Products > Supplier Bacillus Subtilis/product Bacillus Subtilis/manufacturing Bacillus Subtilis
Supplier Bacillus Subtilis/product Bacillus Subtilis/manufacturing Bacillus Subtilis
- Tianjin Qingdao
- T/T L/C D/P D/A Credit Card PayPal
You May Like
-
Multi-functional Probiotic Bacteria - Bacillus Subtilis
-
Agricultural Chemical Product Bacillus Subtilis 6
-
High Quality Agricultural Chemical Product Bacillus Subtilis
-
Multi-functional Probiotic Bacteria - Bacillus Subtilis Pangoo-w.gain
-
Feed Grade Cow Feed, Cows Weight Gain (Traditional Chinese Medicine)
-
Laying Hens in the Laying Period Increase the Laying Rate Composite Additive
Product Details
| Type | Other, Bacillus | Use | Cattle, Chicken, Dog, Fish, Horse, Pig | |
| Admixture (%) | 0.01% | Moisture (%) | 10% Max | |
| Grade | Top | Packaging | 25kg/bag | |
| Place of Origin | Hebei, China | Brand Name | PANGOO | |
| Model Number | PANGOO |
Product Description
Biological feature
It’s one kind of bacillus, gram positive bacteria. One bacterium is 0.7-0.8um×2-3um, coloring evenly, without capsule, with flagella around it, can move. The size of spore is 0.6-0.9um×1.0-1.5um, oval or columnar, at central or a little near center of the bacterium; the bacterium will not expand after spore forms. The surface of the bacteria colony is rough and opaque, with the color of dirty white or yellow, usually form wrinkle pellicle during growing in the liquid culture medium. They are aerobic bacteria, can use protein, a variety of sugar and starch decompose tryptophan and form benzpyrole.
Principle
1.The active substances like subtilin, polymyxin, nystatin, gramicidin and etc. Generated during the growing period of bacillus subtilis, have obvious inhibiting function to pathogenic bacteria.
2. They can exhaust the free oxygen in the environment rapidly, make the intestinal tract hypoxia, promote the beneficial anaerobic bacteria growing, and generate the organic acid like lactic acid and etc., reduce the PH value of intestinal tract, inhibit the growth of other pathogenic bacteria indirectly.
3. They can stimulate the growth and development of the immune organ of animals, activate lymphocyte T, B, lift the level of immune protein and antibody, enhance the functions of cell immunity and humor immunity, and enhance the immunity of the group.
4. The bacillus subtilis can compound α-amylase, protease, lipase, cellulase and etc. by themselves, and play a role with digestive enzymes inside animals in the digestive tract.
5. They can compound several kinds of vitamin group B like vitamin, niacin and etc., enhance the activity of interferon and macrophage inside animals.
For aquaculture farming
1. To purify water.
2. To inhibit the over reproduction of the harmful algae. It can inhibit the over reproduction of the harmful algae in the culturing pond, and cut off the nutrient source of the vibrio and photogenic bacteria, inhibit their growth, keep the water quality steady.
3. To improve the substrate. It can remove the mud, adjust and steady the water PH value.
4. To enhance the health. It can enhance the aquatic animals’ immunity, strengthen their constitution, increase the survival rate and growing speed, and enhance the anti-stress ability.
5. As the food of the aquatic animals. The beneficial bacteria colonies are the good food for the aquatic animals, including the rich active nutrients to promote the growth and enhance the immunity of the aquatic animals.
For poultry and livestock
1. They are antioxidant, can bear compress and high temperature, they can be in the high temperature of 60°C for a long time, and live for 20 minutes in the temperature of 120°C, they can bear acid-base, can keep activity in the acidic stomach environment, they can bear the attack of saliva and bile, they are the living bacteria straight arrive large and small intestines of 100 percent in the feed microorganisms.
2. They can protect against the gastrointestinal diseases like diarrhea, scouring and etc.
3. They can promote the digestion and absorption, increase feed using, prevent animal from indigestion..
4. They can reduce the using of antibiotic, enhance the immunity.
5. They can control bacterial disease, remove bad smell and flying, reduce the pollution to the environment.
6. They can improve the quality of meat, eggs and milk, increase pigmental degree and eating flavor naturally. Make pigs good red skin and bright fur; darken the color of meat chicks and meat ducks; improve the quality and color of eggs shell, make egg white thick, egg yolk bright red; make aquatic animals more healthy and spotless.
Technology
Super bio-gene phenotype induction technolygy
Equipment
Our professional equipment for our probiotics production
Service
We are here 24 hours!
ST (Super bio-gene phenotype induction Technology)
QUALITY MENAGEMENT SYSTEM CERTIFICATE
Cer. NO.: 10615Q10106R0S
CERTIFICATE OF FOOD SAFETY MANAGEMENT SYSYTEM CERTIFIATION
Cer. NO.: 115FSMS1500056
ISO 9001:2008
Cer. NO.: CN1421471
Contact Us
- Cangzhou Pangoo International Trade Co., Ltd.
- Contact nameAnna Zhao Chat Now
- Phone86-317-5679918
- AddressRoom2-1104,NO.1 building,Yudayijing, Yuhe road, Cangzhou city, Hebei province, China, Cangzhou, Hebei
Product Categories
| New Products |
New Products
-
Cows Weight Gain (Traditional Chinese Medicine)
-
ZYM-F17 Trepang Feed Fermentation Bacteria
-
Calf Feed for the Cow , Cattle
-
Specialized Bacterium for Wastewater Treatment , Free Trial Order
-
Aquatic in Trepang Feed Fermentation Bacteria we Are Factory
-
OBP-F13 Highly Active Feed Yeast in China
-
OBP-F13 Highly Active Feed Yeast in Field in China
-
Famous Traditional Chinese Painting, Ink Wash Painting,Painting by Zhu Xiuxuan
-
Bacillus Licheniformis Probiotics in Feed Additives High Concentration
-
Buy Bacillus Licheniformis/feed Grade Probiotics Supplier Bacillus Licheniformis
-
Feed Additives Probiotic Bacillus Subtilis%bacillus Licheniformis&clostridium Butyricum ex Our Own Factories
-
Natural Health Supplement Bacillus Licheniformis Natural Probiotics for Animal Feed
-
Probiotic Bacillus Licheniformis for Aquaculture Made in China Bio-gain em Aqua
-
High Quality Probiotics 200 Billion Cfu/g Bacillus Licheniformis for Animal Feed Additives Companies
-
High Quality Bacillus Subtilis Feed Additives Shrimp Probiotic Fermentation 400 Billion Cfu/g wp
-
Bacillus Subtilis Feed Additives Shrimp Probiotic Fermentation 400 Billion cf Bacillus Licheniformis 400billion Highly Effective
-
High Quality Probiotics Feed Additives----bacillus Licheniformis
-
Feed Additive of Bacillus Licheniformis p
-
Feed Additive of Compound Enzymes of Bacillus Subtilis / Bacillus Licheniformis / Lactobacillus
-
Bacillus Subtilis Feed Additives Shrimp Probiotic High Quality Prebiotics 6
-
Bl2000(200 Billion) Bacillus Licheniformis Probiotics in Feed Additives
-
China Supplier Bacillus Licheniformis Probiotics Bulk for Feed Supplement
-
Probiotic Drink Powder Bacillus Subtilis Bacillus Licheniformis Clostridium Butyricum China Manufacturer
-
High Quality Bacillus Subtilis Feed Additives Shrimp Probiotic High Quality 400 Billion Cfu/g wp
Popular Searches
- drinking bowl
- baby feeding bottle
- baby pacifier food
- feeding bottle nipple food
- breast enlargement pump
- drinking set
- cotton seed meal
- silicone bowl
- milk collector
- health care kit
- lick block
- baby spoon
- silicone shield
- baby set
- breast pump
- car wash box
- pacifier clip
- baby pacifier
- baby pacifier clip
- silicon baby pacifier clip
- baby pacifier holder clip
- chain pacifier clip
- baby pacifier chain clip
- rape seed meal
- silicone nipple
- baby nipple
- baby bowl
- pp feeding bottle
- pacifier
- baby feeder
Recommended Products
- Squid Liver Powder
- Soybean Lecithin
- Squid Liver Paste
- How to Choose the Right Animal Feed Pellet Machine
- Corn Steep Liquor Powder for Fermented Feed
- FRP Products For Livestock Farming
- Artemia Cysts,brine Shrimp Eggs
- Hatchery Feed,artemia Cysts,brine Shrimp Eggs
- Feed Magnesium Oxide
- Corn Steep Liquor Powder for Feed & 43% Protein
- Brine Shrimp Eggs,artemia Cysts
- Artemia Cysts,brine Shrimp Eggs
Find Similar Products By Category
- Agriculture & Food > Fodder, Feed
- Please Enter your Email Address
- Please enter the content for your inquiry.
We will find the most reliable suppliers for you according to your description.
Send Now-
Anna Zhao
Hi there! Welcome to my shop. Let me know if you have any questions.
Your message has exceeded the limit.
- Contact supplier for lowest price
- Customized Request
- Request Sample
- Request Free Catalogs
Your message has exceeded the limit.
-
Purchase Quantity
-
*Sourcing Details
Your inquiry content must be between 10 to 5000 characters.
-
*Email
Please enter Your valid email address.
-
Mobile






Multi-functional Probiotic Bacteria - Bacillus Subtilis
Feed Grade Cow Feed, Cows Weight Gain (Traditional Chinese Medicine)
Laying Hens in the Laying Period Increase the Laying Rate Composite Additive

ZYM-F17 Trepang Feed Fermentation Bacteria
Calf Feed for the Cow , Cattle
Specialized Bacterium for Wastewater Treatment , Free Trial Order
Aquatic in Trepang Feed Fermentation Bacteria we Are Factory
OBP-F13 Highly Active Feed Yeast in China
Famous Traditional Chinese Painting, Ink Wash Painting,Painting by Zhu Xiuxuan
Bacillus Licheniformis Probiotics in Feed Additives High Concentration